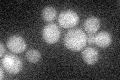
YIL045W
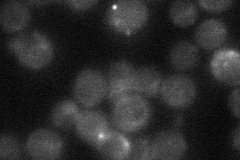
YIL045W
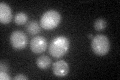
YIL045W
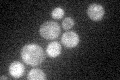
YIL045W

View description
Putative type-1 protein phosphatase targeting subunit that tethers Glc7p type-1 protein phosphatase to Gsy2p glycogen synthase
Localization:
Intensity:
Fold change:
Significance:
-
C’ GFP library in SD
cytosol19.69 -
N' NOP1pr-GFP in SD

cytosol,punctate57.1265 -
N' TEF2pr-mCherry in SD

cytosol,punctate6.38653 -
N' NATIVEpr-GFP in SD
punctate22.4239 -
N' TEF2pr-VC and Cyto-VN in SD

punctate41.7334 -
C’ GFP library in SD+DTT
cytosol20.941.06No -
C’ GFP library in SD+H2O2

cytosol21.031.06No -
C’ GFP library in Starvation Media
cytosol25.241.28No -
C’ GFP library on the background of Pup2-DaMP

N/A -
C’ GFP library on the background of CCT mutant

N/A0N/AYes
